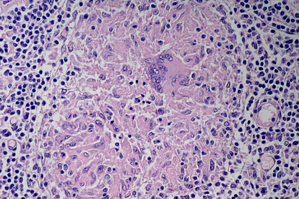

Болезнь Крона – хроническое рецидивирующее воспалительное заболевание желудочно-кишечного тракта аутоиммунной природы, характеризующееся поражением всех его отделов, начиная от полости рта и заканчивая прямой кишкой и анальным каналом. Чаще всего патологический процесс затрагивает конечный отдел тонкой кишки (подвздошную кишку) или толстую кишку (ободочную и прямую). Некоторые больные имеют длительные ремиссии, которые продолжаются в течение нескольких лет. При этом никакие симптомы заболевания не проявляются. Однако через какое-то время недуг обязательно даёт о себе знать.
В последнее время в экономически развитых странах отмечается рост заболеваемости болезнью Крона. Первичная заболеваемость на данном этапе составляет от 2 до 4 человек на 100 000 населения в год, а общая распространенность — 30-50 случаев на 100 000 населения. Например, в Великобритании регистрируется 1 больной на 2000 жителей страны, а в западной части Ирландии число заболевших составляет уже до 1 человека на 300 единиц населения. Как часто случается в медицинских кругах, болезнь названа в честь американского гастроэнтеролога Баррила Бернарда Крона, который в 1932 году вместе с двумя коллегами (Леоном Гинзбургом и Гордоном Д. Оппенгеймером) опубликовал первое описание 14 случаев данного заболевания.
Причины. Болезнь может возникнуть у совершенно здорового человека, причём в любом возрасте, но чаще всего появляется между 15 и 35-40 годами. Чаще всего недуг возникает у людей, живущих в северных странах, он поражает мужчин и женщин в равной степени и часто является локально распространённым в пределах одной семьи. Другими словами, около 20% пациентов с болезнью Крона имеют родственника, чаще всего брата или сестру, но иногда и одного из родителей, страдающего той или иной формой воспалительных заболеваний кишечника. В настоящее время нет единого взгляда на этиологию воспалительного процесса. Основные теории: инфекционная (Mycobacterium paratubercolosis) и вирусная (вирус кори). Важную роль в развитии заболевания играют также генетическая предрасположенность и иммунодефицитные состояния организма больного, то есть нарушения механизмов иммунной защиты слизистой оболочки кишечника. У пациентов выявляются антитела к ткани толстой кишки, специфически сенсибилизированные к антигенам слизистой толстой кишки лимфоциты. Повреждающее действие оказывают также иммунные комплексы. Все это приводит к выраженным воспалительным изменениям кишечника, поражаются также желудок и пищевод.
Симптомы заболевания могут резко отличаться у разных людей в виду того, что болезнь Крона способна поражать любой отдел пищеварительного тракта. В общем и целом признаками наличия недуга могут являться:
- Боли в животе, спазмы (это классический симптом, проявляющийся в 85-90% случаев)
- Диарея (примеси крови и слизи в кале – в 66% случаев)
- Потеря веса, анорексия (обусловленные усилением боли после приёма пищи – в 55% случаев)
- Тошнота, рвота
- Боль в заднем проходе при дефекации
- Вздутие живота
- Абсцессы (свищи) прямой кишки
- Анальные трещины
- Со стороны других органов: боли в суставах (артрит), поражения кожи (эритемы), конъюнктивит, стоматит, цистит
Общими симптомами являются слабость, усталость, повышение температуры, часто волнообразного характера.
Лечение неосложнённой болезни Крона проводится фармацевтическими препаратами (группами лекарственных средств сульфасалазина и глюкокортикоидов). Пациентам назначается диета с увеличенным содержанием легкоусвояемых белков (рыба, белое мясо) и ограничениями на потребление молочных продуктов, свежих фруктов и овощей. Хирургическое вмешательство показано при осложнениях, среди которых основными являются кровотечения, токсическая дилатация (резкое вздутие кишки), перфорация в брюшную полость (сквозной дефект в стенке желудка или кишки), инфильтраты, абсцессы и кишечная непроходимость. До 70 % пациентов с болезнью Крона в течение жизни подвергаются тому или иному оперативному вмешательству. Хирургическое лечение часто приводит к длительному облегчению симптомов болезни, снижает или устраняет необходимость в постоянном использовании лекарств. Однако важным условием снижения частоты рецидивов после операции остаётся адекватная медикаментозная терапия.
на фото: гранулёма в стенке толстой кишки

Чтобы оставить комментарий, необходимо авторизоваться